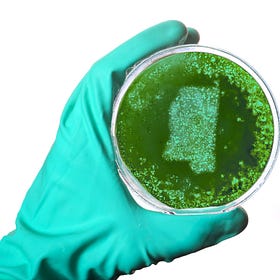
Expanding Medicaid for Black women in the Delta could save lives—and the state budget

Evening Roundup, March 18
Another big win for Norm & SDD; plus features from Sarah Godlewski; Gabe Lezra, Diamond Brown, Siven Watt & Francois Barrilleaux; Brian O'Neill; Rushab Sanghvi; Shirley Atkins; Josh Levs; & Mimi Rocah
Good evening Contrarians! We are thrilled to announce that our publisher Norm Eisen, along with the brilliant legal team at State Democracy Defenders, received a huge ruling today. This one was a primary injunction stopping DOGE from dismantling USAID. The judge ordered that all employees be given back their emails and accounts and have access reinstated. Another incredible win for democracy and the rule of law…and your support helped secure it! Learn how it feels to ensure that DOGE and Musk halt further activity by joining Norm and Jen tomorrow morning at 9:15 a.m. on Substack Live for your dose of Coffee with the Contrarians! As always, thank you for being with us.
Before the ruling, our fearless leaders had a chat about what was filed and what was at stake:
Ethics Complaint in WI Targets Elon-backed Organization
Yesterday, an ethics complaint was filed with the Wisconsin Ethics Commission against Building America’s Future, a political organization backed by Elon Musk. The complaint alleges that the organization failed to disclose its express advocacy spending, which is in violation of Wisconsin law. Jen and Norm explain more.
Wisconsin’s Supreme Court: The next battleground for democracy
A powerful billionaire thinks he can buy votes in our state. But our courts and our democracy are not for sale.
By Sarah Godlewski
15 Ways You Can Fight for Democracy
By Gabe Lezra, Diamond Brown, Siven Watt, and Francois Barrilleaux
Every day, hundreds of family members, friends, and Contrarian readers reach out to ask what they can do to stop Trump and turn the tide against autocracy. We can help!
Rushab Sanghvi and Jen on the Importance of Labor Unions
As the Trump-Musk regime continues to threaten thousands of government employees, Jen Rubin and Rushab Sanghvi discuss the critical importance that unions play in protecting our civil servants. (VIDEO)
Expanding Medicaid for Black women in the Delta could save lives—and the state budget
A middle-aged Black woman from the Mississippi Delta, is an example of a troubling and preventable reality. When her child aged out of Medicaid eligibility, she lost her own coverage, cutting her off from regular access to health care.
By Shirley Atkins
Trump’s Yemen strikes: A playbook of escalation, distraction, and hubris
The Houthis have been fighting, and surviving, attacks for a long time. The right approach takes patience and precision.
By Brian O’Neill
Legacy media fail to fact check Trump’s ‘border czar’ on sex trafficking
For months, millions of people who watch Fox News have been told they’re living in a dystopian society in which the horrific scourge of sex trafficking has increased by a whopping 600% over the past four years. This claim has come from Tom Homan, now Trump’s border czar…
A Tipping Point at the Department of Justice
Trump and his enablers have crossed a new bridge into autocratic territory
By Mimi Rocah

Thank you Norm and Jen!!!! It is great to get honest news and support legal proceedings upholding the constitution all at the same time!!!!
We have to have a platform and a leader. The courts need us in the streets now to support their gavel. You thought there were only 3, but we have 5 branches. The media is the 4th branch, and we the people are The 5th branch of this government. We march when we have had it. We have had it. March on DC! https://hotbuttons.substack.com/p/a-just-movement?r=3m1bs